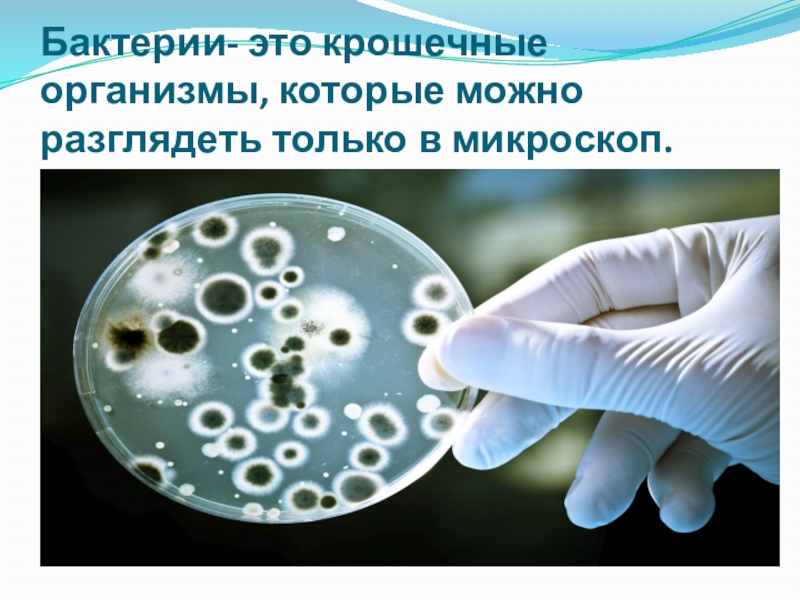

- Главная
- Разное
- Образование
- Спорт
- Естествознание
- Природоведение
- Религиоведение
- Французский язык
- Черчение
- Английский язык
- Астрономия
- Алгебра
- Биология
- География
- Геометрия
- Детские презентации
- Информатика
- История
- Литература
- Математика
- Музыка
- МХК
- Немецкий язык
- ОБЖ
- Обществознание
- Окружающий мир
- Педагогика
- Русский язык
- Технология
- Физика
- Философия
- Химия
- Шаблоны, фоны, картинки для презентаций
- Экология
- Экономика
Презентация, доклад по окружающему миру по теме Бактерии
Содержание
- 1. Презентация по окружающему миру по теме Бактерии
- 2. Бактерии- это крошечные организмы, которые можно разглядеть только в микроскоп.
- 3. Много бактерий живет в воде, воздухе, еде, внутри и снаружи живых организмов
- 4. Слайд 4
- 5. Большое число бактерий селится в гниющих фруктах, деревьях, останках живых существ и питается этой пищей.
- 6. Большинство бактерий размножается делением.
- 7. Бактерии бывают плохие и хорошие.
- 8. Спасибо за внимание!
Бактерии- это крошечные организмы, которые можно разглядеть только в микроскоп.
Слайд 5Большое число бактерий селится в гниющих фруктах, деревьях, останках живых существ
и питается этой пищей.